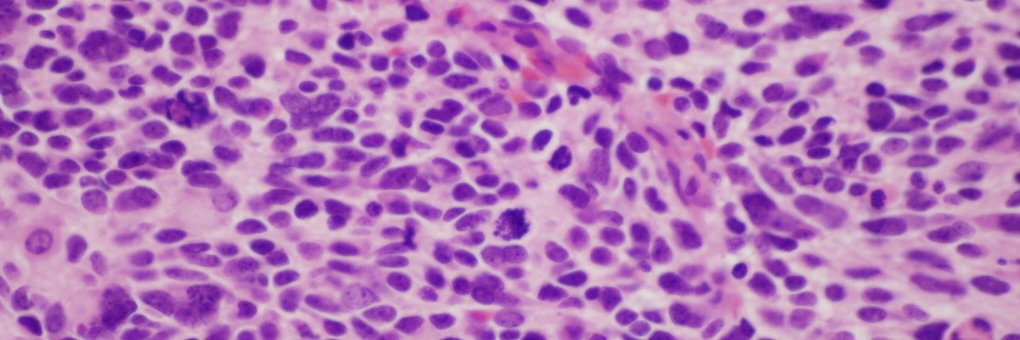
Jason Jarzembowski banner

Jason Jarzembowski retweetledi
Jason Jarzembowski
2.1K posts

Jason Jarzembowski
@smallbluecells
CEO, Children's Specialty Group; Lab Medical Director, @childrenswi; Vice Chair for #pedipath @MedicalCollege; Pathology Chair, @COGorg; T/RT not medical advice
Milwaukee, WI Katılım Aralık 2015
405 Takip Edilen1.9K Takipçiler
Jason Jarzembowski retweetledi

ISIMM Webinar - IHC Correlates of the 5th Edition WHO Classification of Pediatric Tumors with Jason Jarzembowski - mailchi.mp/isimm/2025-165…

English
Jason Jarzembowski retweetledi

Important paper on peripheral neuroblastic tumors #Neuroblastoma, frequently seen in #PediPath Thanks to our colleagues, Jason Jarzembowski @smallbluecells, Samuel Navarro and Hiroyuki Shimada. I'm sure you'll find it helpful! link.springer.com/article/10.100…

English

@lbsmithmd @DrChuanChen Ah, great memories! I remember calling @lbsmithmd to tell her I might be late or unable to attend her dinner for the first year residents and she thought I was kidding about all the autopsies!
English

@DrChuanChen ouch! I remember @smallbluecells getting 4 his first Saturday in call when we were first years. Black cloud!
English

@TeamCaptainJohn I’m with you if we can name the Epic module “Dracula.”
English

1.) form a team of transfusion medicine professionals and coders to build a blood bank LIS that doesn’t suck
2.) ?????
3.) sell to #Epic
4.) profit $$$$
Who is with me?
English
Jason Jarzembowski retweetledi
Jason Jarzembowski retweetledi

Humbled. Grateful. Proud. These words come to mind as we have been named a @journalsentinel Top Workplace for the 15th year in a row. This award recognizes southeastern WI businesses on qualities such as company leadership, career opportunities, workplace flexibility and more.

English

Just wanted to point out that nobody in the tournament has hung closer to UConn or held them to fewer points than @NorthwesternU! #gocats 😼
Wisconsin, USA 🇺🇸 English
Jason Jarzembowski retweetledi

Abstract and Bursary Applications are now open for the IAP 35th International Congress in Cancun, Mexico.
Abstract Application deadline: May 6
Bursary Application deadline: May 13th.
See the IAP website for details: iapcentral.org

English
Jason Jarzembowski retweetledi

Our favorite Directory image of the week is from Jason A. Jarzembowski, M.D., Ph.D. @smallbluecells
Subspecialty: Pediatric
Diagnosis: Neuroblastoma
Dr. Jarzembowski's profile: buff.ly/3vpioL0
#pathology #pathologyoutlines #profile #image #pediatric #PathTwitter

English
Jason Jarzembowski retweetledi

Children's Wisconsin CEO Peggy Troy plans to retire by the end of next year after more than a decade in the role jsonline.com/story/news/hea…
English
Jason Jarzembowski retweetledi

The one and only Dr. Jake Mandziuk presents a rare case of generalized arterial calcification of infancy at the perinatal case session of #SPPFall2023 in Portland. #pedipath @SocPediPath @childrenswi @mcwpathology @UAlberta

English
Jason Jarzembowski retweetledi

when you put too much OCT on the chuck during #frozensection & have to really dig in to face the block
English
Jason Jarzembowski retweetledi

The WHO Classification of Tumours: Paediatric Tumours is now available in print.
This is Volume 7 of the 5th edition of the series.
We take this opportunity to thank Dr @IanCreeUK for his exceptional leadership during his time as Head of the #WHOBlueBooks
iarc.who.int/news-events/pu…

English
Jason Jarzembowski retweetledi

Congratulations to our finishing fellows @cmaloney212 (senior fellow) and @ZMorrison226 (critical care fellow)!
Dr. Maloney will be joining the @MCWSurgery #pediatricsurgery group as our newest faculty!
Dr. Morrison will be starting a surgical oncology fellowship at @StJude.

English
Jason Jarzembowski retweetledi
Jason Jarzembowski retweetledi
Jason Jarzembowski retweetledi

Need some weekend reading? Congenital Pulmonary Airway Malformations With a Reconsideration and Current Perspective on the Stocker Classification. Free access period ends June14th!
journals.sagepub.com/doi/full/10.11…
English
Jason Jarzembowski retweetledi

We are grateful to Dr. Ian Cree for his leadership & most successful tenure at @IARCWHO and remarkable 5th series of the WHO Blue Books on tumor classifications. Ian and the IARC team are to be congratulated @ESP_Pathology @IanCreeUK @TheUSCAP

English









